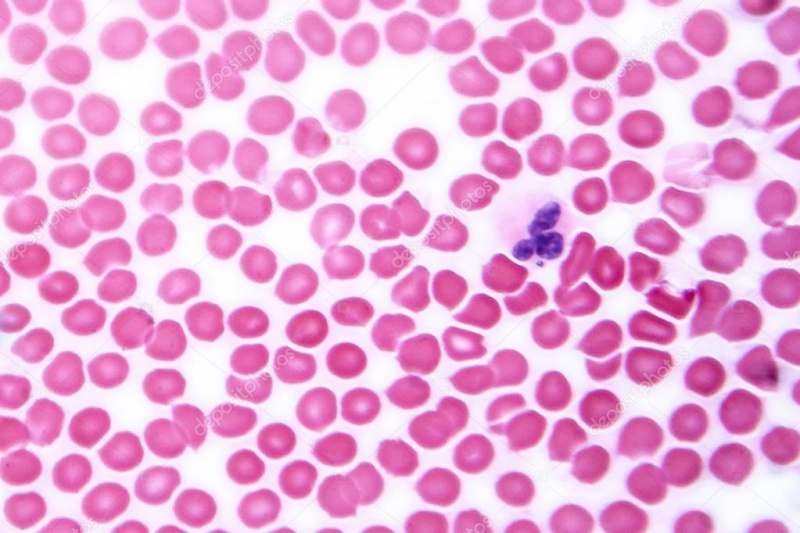

Клітини та тканини тварин. ЗНО
Процеси формування тканин в онтогенезі
До тканин внутрішнього середовища відносяться:
Група клітин, які мають подібну форму і виконують однакові функції та мають спільне походження , називають:
Позначте тканину, яка відсутня в рослин:
Укажіть, до якої групи тканин належить кров:
Укажіть, яких тварин називають тришаровими:
Укажіть органи, утворені багатошаровим епітелієм:
Укажіть тканину, багату на міжклітинну речовину:
Визначте, яка тканина НЕ належить до сполучної:
Укажіть характерну особливість будови нервової тканини
Укажіть тканину, що утворює внутрішній шар порожнистих органів тварин:

Цифрою 1 на малюнку позначено :

Цифрою 5 на малюнку позначено :
Довгий відросток нейрона
До м’язової тканини відносятся:

Цифрою 4 на малюнку позначено :

Яка тваринна тканина має наступні характеристики та функції: складається із зірчастих клітин-нейронів, які здатні сприймати подразнення та передавати керівні сигнали від мозку до органів; відбувається регуляція всіх функцій організму.
Визнач вірні твердження: 1) клітини внутрішнього середовища перебувають на значній відстані одна від одної.
2) м'язові тканини притаманні лише тваринам
Виберіть тканини, що мають багато міжклітинної речовини
Виберіть ознаки, щзо відрізняють тварин від інших живих організмів
Прочитай твердження. Визнач, яке/які є правильне/ні.
- серед тваринних тканин є такі, що перебувають у рідкому стані.
-міжклітинна речовина майже відсутня в епітеліальних тканинах..
Які ознаки живого притаманні тваринам?
Вказати які типи тканин характерні для тварин?

Глікоген запасається у клітинах....
Тканина на фото:

Вказати тип тканини зображеної на малюнку

Яка тканина зображена на фото

Укажіть тканину, зображену на рисунку:
Які функції виконує епітеліальна тканина
Серед запропонованих малюнків оберіть зображення кісткової тканини
Серед запропонованих малюнків оберіть нервову тканину
До клітин крові належать
Якої тканини немає в організмі тигра бенгальського?
Ця тканина забезпечує потужні швидкі скорочення скелетної мускулатури
Клітини цієї тканини сприймають подразнення і відповідають скороченням
Тканина , що утворює скелет,сухожилля, забеспечує живлення інших тканин,
здійснює транспорт речовин,виконує захистну функцію
Особливостям епітеліальної тканини є:
Посмуговані м'язові волоконця входять до складу:

Укажіть, яку структуру нейрона позначено цифрою 4:

Яка тканина зображена на фото??

Який різновид м`язової тканини зображено на фото?
Опорна й захисна функція.
Дійсний дифтерійний круп виникає внаслідок відкладання на справжніх голосових зв'язках фібринових плівок, міцно
зв'язаних з епітелієм. Яким з означених нижче типів епiтелiю утворена слизова оболонка цих голосових зв'язок?
Що може утворюватися за рахунок клітин покривного епітелію? (декілька відповідей):
Як називаються клітини, з яких складається нервова тканина?
Який вид м'язової тканини входить до складу стінок внутрішніх органів (кишківника, судин)?
Розставте рівні організації організму тварини від найменшого до найбільшого
Яка з тканин внутрішнього середовища має міжклітинну речовину з органічних речовин і формує скелет у зародків хребетних тварин і людини?
Яка відмінність допоміжних клітин нервової тканини (нейроглії) від нейронів?

Створюйте онлайн-тести
для контролю знань і залучення учнів
до активної роботи у класі та вдома


























